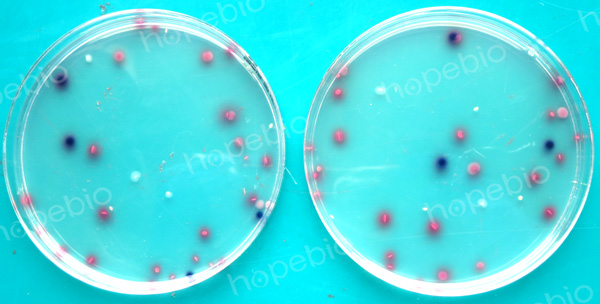

海博微信公众号
海博微信公众号
 海博天猫旗舰店
海博天猫旗舰店


 海博微信公众号
海博微信公众号
 海博天猫旗舰店
海博天猫旗舰店




一、试验原理:
大肠杆菌/大肠菌群显色培养基(第二代)是青岛海博生物公司再次改良的培养基,用于食品、水、牛奶、冰激凌和肉制品中大肠杆菌和大肠菌群的快速检测。大肠杆菌和大肠菌群分别具有特异性的酶,利用其分解底物得到产物的不同来区分大肠杆菌和大肠菌群。大肠杆菌显蓝色至紫色,大肠菌群显红色,革兰氏阳性菌被抑制。
二、培养基配方(g/L):
|
特殊营养物质 |
33.0 |
|
显色剂 |
0.3 |
|
琼脂 |
13.0 |
|
pH 6.8-7.2 25℃ |
|
三、试验方法:
1.称取本品46.3g加入1000ml蒸馏水,加热溶解并不停搅拌,煮沸不要超过1分钟。取1ml制备好的样品液加入直径为9cm无菌平皿中心,倾入冷却至45-50℃ 培养基约15ml,混匀,凝固后,再加入一层培养基进行履盖。 或冷却至45-50℃时,倾入无菌平皿,琼脂完全凝固后,在37℃的培养箱中倒置放置1-2小时,加入适当稀释度的样品液1ml,涂布于培养基上,36℃培养18~24h。
2.选用有30~200个菌落的平板,计数平板上出现的典型大肠菌群和大肠杆菌菌落。大肠杆菌典型菌落为蓝色至紫色,大肠菌群为粉红色菌落,其它细菌为无色或黄色菌落;
总大肠菌群=蓝色菌落+紫色菌落+粉红色菌落
大肠杆菌=蓝色菌落+紫色菌落。
3.对可疑大肠杆菌菌落可划线接种到营养琼脂平板上,36℃培养12-16小时,挑取单菌落做大肠杆菌全套生化试验(本公司有生化鉴定管套装4种x4套)。
四、结果观察与解释
在36℃培养18~24h小时:
|
质控菌株 |
ATCC |
生长情况 |
菌落颜色 |
|
金黄色葡萄球菌 |
25923 |
-/+ |
无色 |
|
大肠杆菌 |
25922 |
+++ |
蓝色 |
|
沙门氏菌 |
14028 |
+++ |
无色 |
|
阴沟肠杆菌 |
23355 |
+++ |
粉红色 |
|
产气肠杆菌 |
35029 |
+++ |
粉红色 |
|
弗氏柠檬酸盐杆菌 |
43864 |
+++ |
粉红色 |
|
肺炎克雷伯氏菌 |
10031 |
+++ |
粉红色 |
图1典型特征:大肠杆菌典型菌落为蓝色至紫色,大肠菌群为粉红色菌落,其它细菌为无色菌落。
相关产品:
注:本文属海博生物原创,未经允许不得转载。
上一篇:蛋白胨水生化管原理和使用方法
下一篇:SOC培养基的实验原理和质控方法
| 相关文章: | ||



